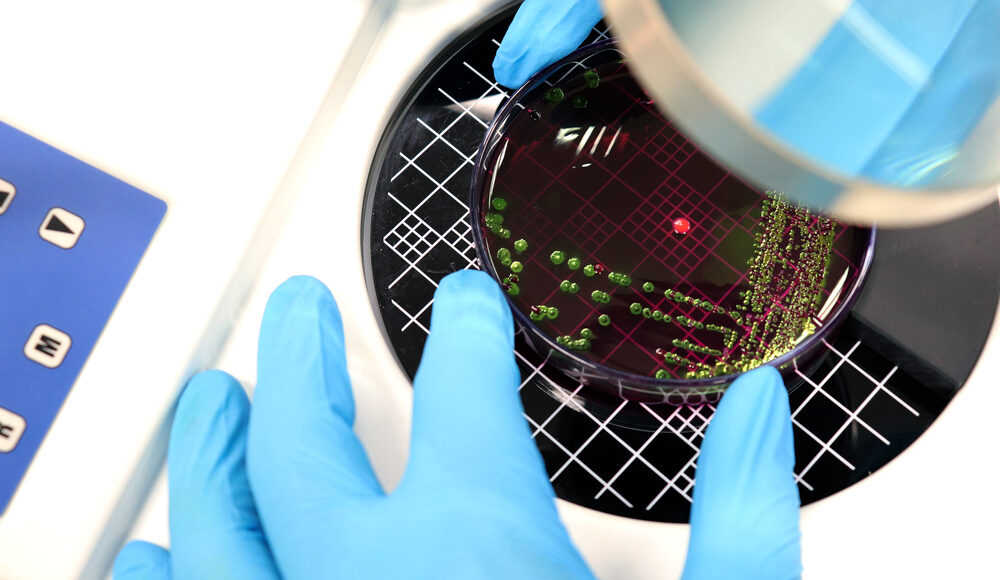
Bacterial count in next-generation probiotics: AFU technology

Bacterial count in next-generation probiotics: AFU technology
Classical methodologies and current limitations Switching from a liquid medium to sold agar plates in the early 1800s was a significant change for microbiology sciences. Operational standardisation of plate counting […]